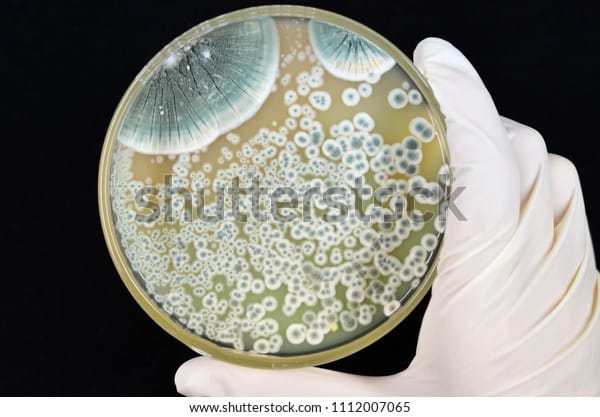
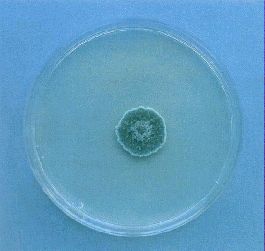
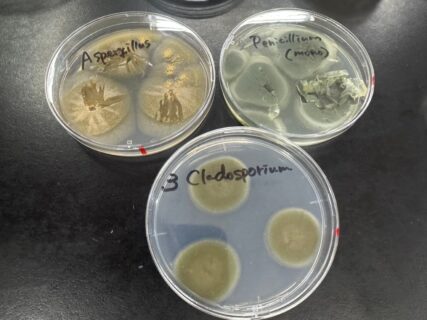

ペニシリン カビ 毒 (422 無料写真)
我が州が誇る青カビNature ダイジェストNature Portfolio。
カビから見つかった薬!カビは医薬品のもと?ネットdeカガク。
カビ多様 薬にも毒にも 紅麹サプリ健康被害:地域ニュース : 読売新聞。
ペニシリン penicillinChem-Stationケムステ。
食品の損傷を引き起こし、最初の抗生物質ペニシリンの生産に使用される真菌ペニシリウムです。分生胞子と Conidiophore の胞子を示す 3 Dの図の写真素材・画像素材 Image 89447205。
プベルル酸とは?プベルル酸の毒性と紅麹との関係についてひまわり医院 内科・皮膚科。
ゴキブリ、アリゲーター、未開の洞窟 人類をバクテリアから救う3つのヒントログミーBusiness。
カビ。このありがたくも迷惑なもの - お役立ち情報株式会社エムエムインターナショナル。
NO.254:牛の病気―頭部― 12有限会社シェパード中央家畜診療所 - Part 1000。
カビが作る毒の話 衛研ニュースNo.123神奈川県衛生研究所。
Penicillium Corylophilumによる食品汚染の概要 - Genspark。
抗がん剤の種「テルペンドールE」の生合成メカニズムを解明理化学研究所。
カビ毒の自然毒を分かりやすく解説 薬剤師国家試験対策マインドマップ薬学。
色で見分けるカビの種類と毒性あすのこベッド Yahoo!店。
化学療法の歴史 サルバルサン,サルファ剤,抗生物質,ペニシリン,スとレプトマイシン。
カビとカビ毒とは?健康への影響と、対策・予防についてブログ高崎市のカビ専門店 いえピカ 女性対応店。
カビ多様 薬にも毒にも 紅麹サプリ健康被害:地域ニュース : 読売新聞。
要注意🍎 パツリン Penicillium expansum とリンゴのカビ毒リスク加工品も安心のためにできる対策プロの作業内容カビ 取り・検査は「カビバスターズ東京」。
化学療法の歴史 サルバルサン,サルファ剤,抗生物質,ペニシリン,スとレプトマイシン。
Penicillium Corylophilumによる食品汚染の概要 - Genspark。
世界初の抗生物質「ペニシリン」の元になったアオカビのDNA配列がやっと解読される!発見当時から"遺伝子が変異していた"という驚きの結果 - ナゾロジ。
ペトリ皿と顕微鏡の下のペニシリンの鋳型のベクターイラスト」のベクター画像素材 ロイヤリティフリー1026773362Shutterstock。
科学の森:カビは「宝の山」、驚きの能力 眠れる力、引き出して医薬品開発毎日新聞。
カビを食べてしまったらどうなる?知っておくべき健康リスク│カビ取り・カビ対策専門業者のカビバスターズ静岡。
カビ多様 薬にも毒にも 紅麹サプリ健康被害:地域ニュース : 読売新聞。
ペニシリウム Penicillium : 湿気の多い場所に潜むカビの脅威と健康リスクカビ予防やカビ除去にまつわるコラムをスタッフが執筆カビ 取り・カビ対策なら素材を傷めないMIST工法カビバスターズ。
要注意🍎 パツリン Penicillium expansum とリンゴのカビ毒リスク加工品も安心のためにできる対策プロの作業内容カビ 取り・検査は「カビバスターズ東京」。
カビってなに??危険なカビと役立つカビ。TJ博士の相談室中部科学機器株式会社。
カビが生み出す猛毒「アフラトキシン」への理解と対策。
プベルル酸とは 小林製薬の「紅麹サプリ」から検出、抗菌作用も毒性強く - 日本経済新聞。
江戸時代からペニシリンを使ってた?医師「足立休哲」はまさにお江戸のブラックジャック!歴史・文化 - Japaaan日本史。
なぜ紅麹サプリで健康被害が起きたのか カビ毒の専門家が「プベルル酸とは断言できない」と慎重になる理由 - ライブドアニュース。
Penicillium Corylophilumによる食品汚染の概要 - Genspark。
カビってなに??危険なカビと役立つカビ。TJ博士の相談室中部科学機器株式会社。
AA: 上宇部こどもクリニック: ペニシリン その1 :1928年フレミング博士の発見。
マイコトキシン類①Penicillium属アオカビ薬剤師国家試験対策学習塾YAKU BASE。
カビってなに??危険なカビと役立つカビ。TJ博士の相談室中部科学機器株式会社。